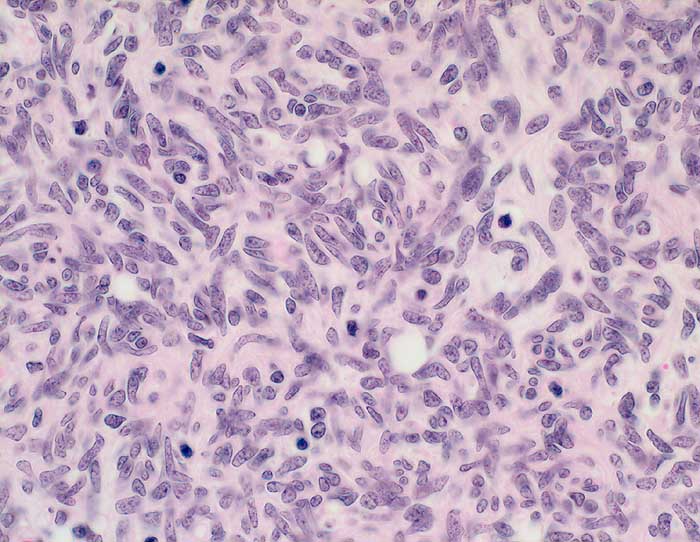

PathoPic – image database / PathoPic ID 5972 - Thymom Typ A (WHO)
de
Diagnose
Thymom Typ A (WHO)
Diagnose Gruppe
benigner Tumor
Topographie
Thymus
Topographie Gruppe
Lunge, Mediastinum mit Thymus
Beschreibung
Spindelige Zellen mit blander Morphologie und eingestreuten kleinen Lymphozyten. Die Spindelzellen zeigen ein angedeutet storiformes Wachstumsmuster.
Zusatzbefund
Makroskopie: 8x6x6cm grosser Knoten, welcher von 3 Seiten von Serosa bedeckt ist. Auf Schnitt hellbrauner gelappter Tumor, welcher durch dicke fibröse Septen unterteilt ist. Der Tumor ist von einer Kapsel umgeben. Kein Durchbruch.
Klinik
Grosser, nach rechts atrial verdrängend wachsender Mediastinaltumor. Hypogammaglobulinämie.
Kommentar
Es handelt sich hier um ein grosses gutartiges Thymom ohne maligne Zellelemente. Der Tumor in überwiegenden Anteilen mit einem medullären Phänotyp mit spindeligen Tumorzellen, entsprechend einem medullären Thymom nach der Müller-Hermelink-Klassifikation und einem Typ A-Thymom nach der WHO-Klassifikation. Der Tumor allseits umkapselt und im Gesunden entfernt ohne invasives Wachstum. Insgesamt hat das Thymom vom Typ A bei vollständiger Umkapselung und Entfernung im Gesunden eine sehr gute Langzeitprognose.
Bilder Typ
Histologie
Vergrösserung
400
Alter
68
Geschlecht
unbekannt
Datum
Ersteintrag: 07.01.2003
Update: 20.07.2004